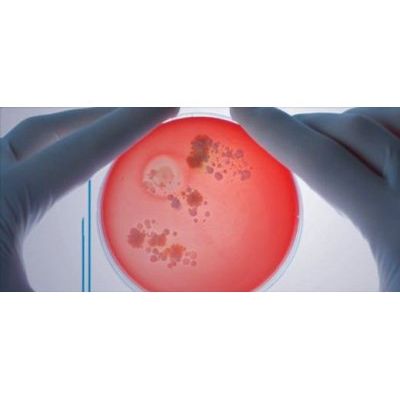

- Home
- Companies
- Bruker Corporation
- Applications
- Drinking water testing - Water and ...
Drinking water testing - Water and Wastewater - Drinking Water
Water is essential for life. It is part of the environment, being used in industrial processes and available as tap water. To secure the safety of water that is daily available, the amount of necessary microbiology tests to comply with regulatory requirements are increasing and are heavily relying on quick and accurate answers to confirm the identities of a broad selection of important micro-organisms.
Regarding the analysis of legionellosis, Legionella pneumophila is the causative agent in natural and man-made water networks. Through aerosol formation it can lead to sporadic and endemic infections mainly of immunocopromised patients. In an outbreak situation fast identification of the causative legionella strain is essential to identify and narrow down the source of infection as promptly as possible. The MALDI Biotyper has the potential not only for rapid identification of L. pneumophila but also to discriminate to the subspecies level overcoming some of the restrictions of currently available technologies that either do not always discriminative or are very time consuming and costly.
